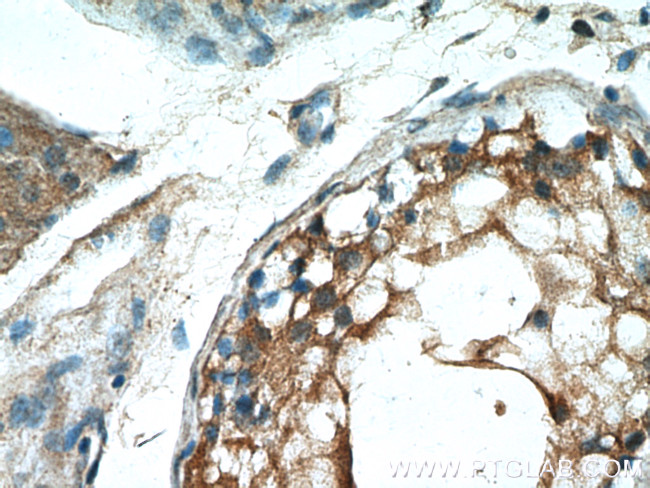
PDILT Antibody in Immunohistochemistry (Paraffin) (IHC (P))
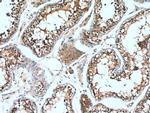
PDILT Antibody in Immunohistochemistry (Paraffin) (IHC (P))

Search
Proteintech
PDILT Polyclonal Antibody
{{$productOrderCtrl.translations['antibody.pdp.commerceCard.promotion.promotions']}}
{{$productOrderCtrl.translations['antibody.pdp.commerceCard.promotion.viewpromo']}}
{{$productOrderCtrl.translations['antibody.pdp.commerceCard.promotion.promocode']}}: {{promo.promoCode}} {{promo.promoTitle}} {{promo.promoDescription}}. {{$productOrderCtrl.translations['antibody.pdp.commerceCard.promotion.learnmore']}}
产品信息
26305-1-AP
种属反应
宿主/亚型
分类
类型
抗原
偶联物
形式
浓度
纯化类型
保存液
内含物
保存条件
运输条件
产品详细信息
Immunogen sequence: KLINDSTNK QELNRVIKQH LTDFVIEYNT ENKDLISELH IMSHMLLFVS KSSESYGIII QHYKLASKEF QNKILFILVD ADEPRNGRVF KYFRVTEVDI PSVQILNLSS DARYKMPSDD ITYESLKKFG RSFLSKNATK HQSSEEIPKY WDQGLVKQLV GKNFNVVVFD KEKDVFVMFY APWSKKCKML FPLLEELGRK YQNHSTIIIA KIDVTANDIQ LMYLDRYPFF RLFPSGSQQA VLYKGEHTLK GFSDFLESHI KTKIEDEDEL LSVEQNEVIE EEVLAEEKEV PMMRKGLPEQ QSPELENMTK YVSKLEEPAG KKKTSEEVVV VVAKPKGPPV QKKKPKVKEE L (235-584 aa encoded by BC042607)
靶标信息
Probable redox-inactive chaperone involved in spermatogenesis.
仅用于科研。不用于诊断过程。未经明确授权不得转售。
篇参考文献 (0)
生物信息学
蛋白别名: protein disulfide isomerase family A, member 7; protein disulfide isomerase-like protein of the testis; protein disulfide isomerase-like, testis expressed; Protein disulfide-isomerase-like protein of the testis
基因别名: PDIA7; PDILT
UniProt ID: (Human) Q8N807
Entrez Gene ID: (Human) 204474